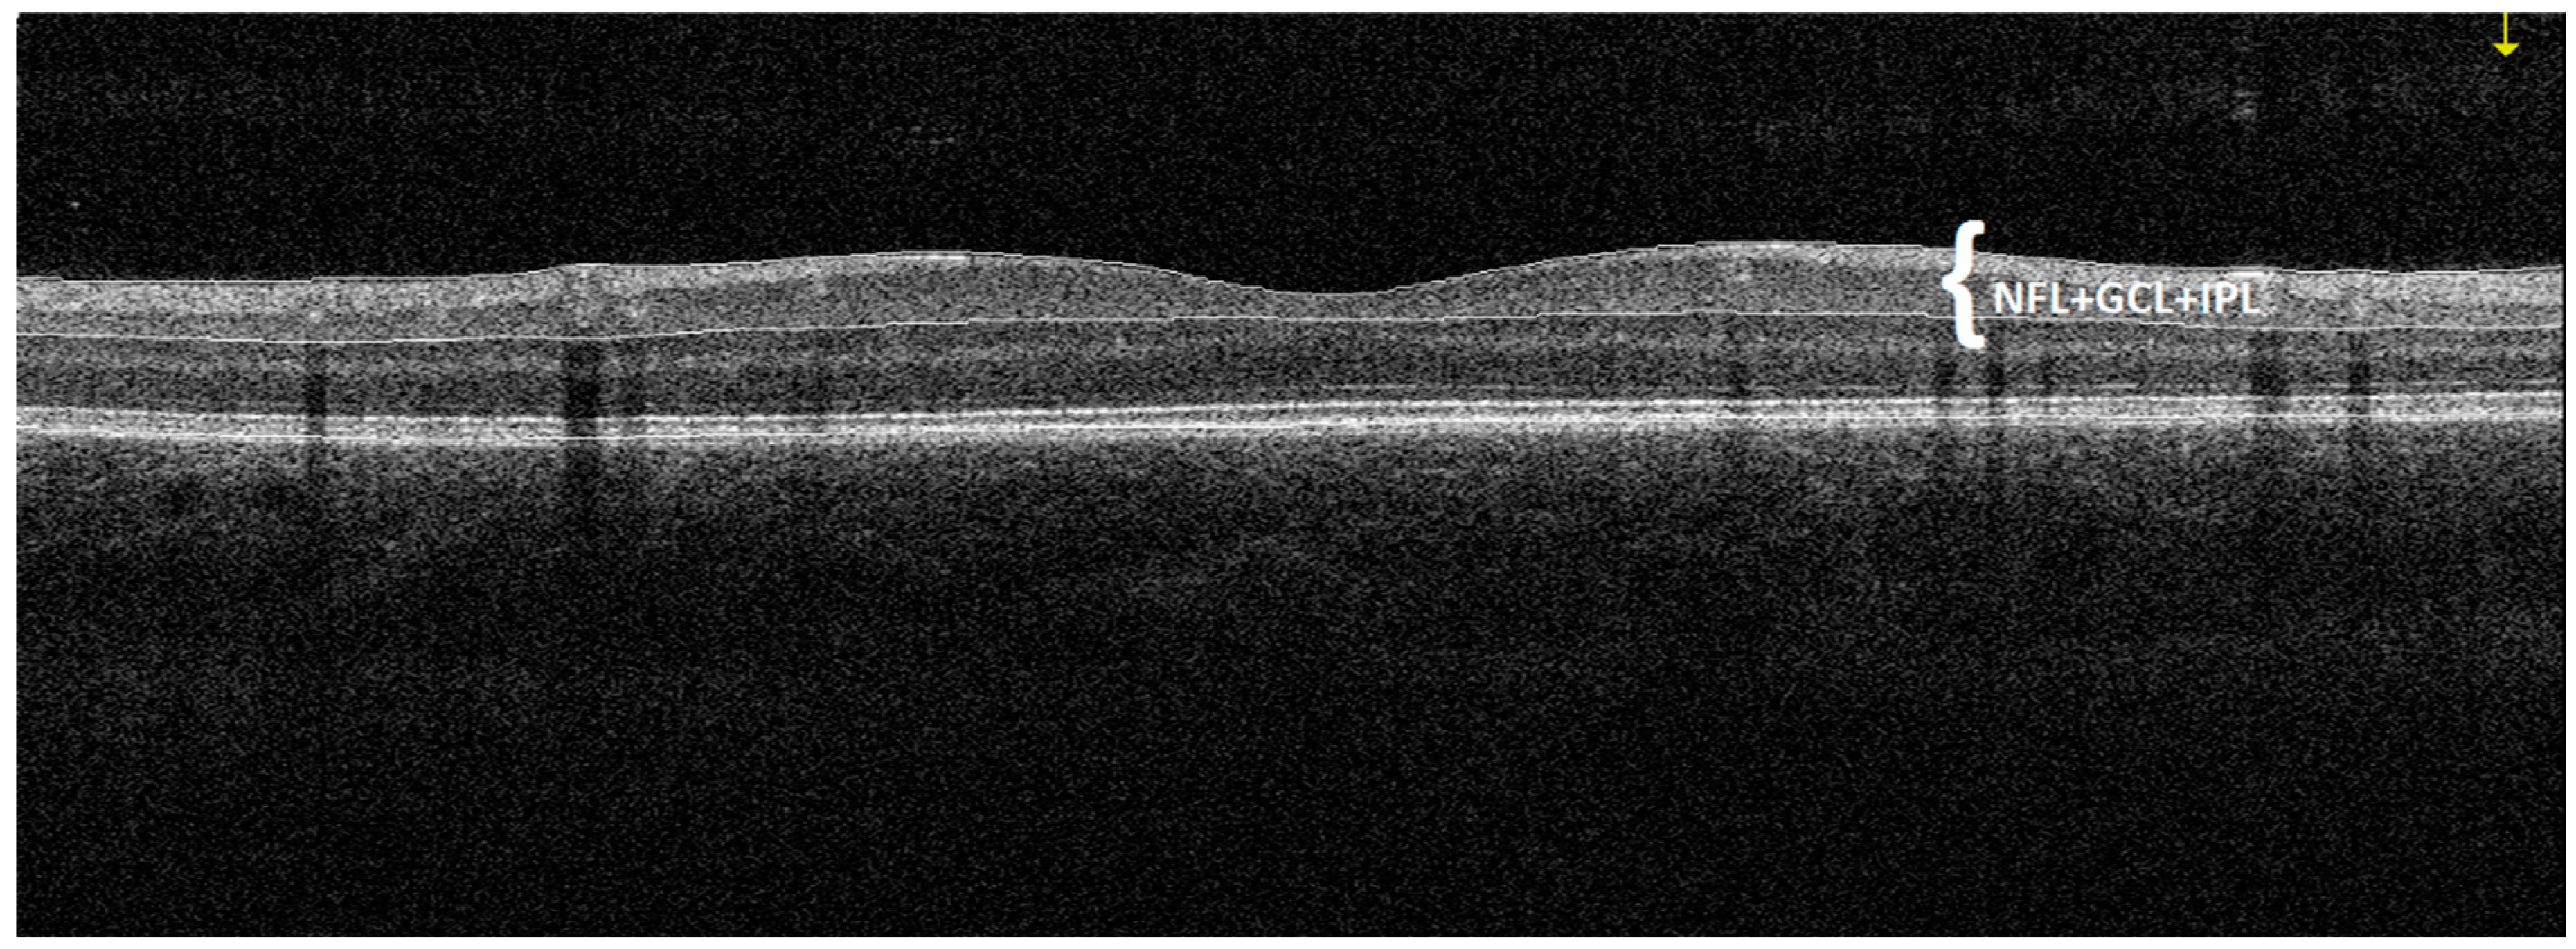

Investigating Ganglion Cell Complex Thickness in Children with Chronic Heart Failure due to Dilated Cardiomyopathy
Abstract
1. Introduction
2. Materials and Methods
3. Statistical Analysis
4. Results
5. Discussion
6. Conclusions
Author Contributions
Funding
Acknowledgments
Conflicts of Interest
References
- Nguyen-Ba-Charvet, K.T.; Rebsam, A. Neurogenesis and Specification of Retinal Ganglion Cells. Int. J. Mol. Sci. 2020, 21, 451. [Google Scholar] [CrossRef] [PubMed]
- Kim, Y.J.; Kang, M.H.; Cho, H.Y.; Lim, H.W.; Seong, M. Comparative study of macular ganglion cell complex thickness measured by spectral-domain optical coherence tomography in healthy eyes, eyes with preperimetric glaucoma, and eyes with early glaucoma. Jpn. J. Ophthalmol. 2014, 58, 244–251. [Google Scholar] [CrossRef] [PubMed]
- Kim, N.R.; Lee, E.S.; Seong, G.J.; Kim, J.H.; An, H.G.; Kim, C.Y. Structure–function relationship and diagnostic value of macular ganglion cell complex measurement using Fourier-domain OCT in glaucoma. Investig. Ophthalmol. Vis. Sci. 2010, 51, 4646–5651. [Google Scholar] [CrossRef] [PubMed]
- Arthur, S.N.; Smith, S.D.; Wright, M.M.; Grajewski, A.L.; Wang, Q.; Terry, J.M.; Lee, M.S. Reproducibility and agreement in evaluating retinal nerve fibre layer thickness between Stratus and Spectralis OCT. Eye 2011, 25, 192–200. [Google Scholar] [CrossRef] [PubMed][Green Version]
- Sharma, P.; Sample, P.A.; Zangwill, L.M.; Schuman, J.S. Diagnostic tools for glaucoma detection and management. Surv. Ophthalmol. 2008, 53, S17–S32. [Google Scholar] [CrossRef]
- Guclu, O.; Guclu, H.; Huseyin, S.; Korkmaz, S.; Yuksel, V.; Canbaz, S.; Pelitli Gurlu, V. Retinal ganglion cell complex and peripapillary retinal nerve fiber layer thicknesses following carotid endarterectomy. Int. Ophthalmol. 2019, 39, 1523–1531. [Google Scholar] [CrossRef]
- La Morgia, C.; Di Vito, L.; Carelli, V.; Carbonelli, M. Patterns of Retinal Ganglion Cell Damage in Neurodegenerative Disorders: Parvocellular vs Magnocellular Degeneration in Optical Coherence Tomography Studies. Front. Neurol. 2017, 8, 710. [Google Scholar] [CrossRef]
- Feng, L.; Zhao, Y.; Yoshida, M.; Chen, H.; Yang, J.F.; Kim, T.S.; Cang, J.; Troy, J.B.; Liu, X. Sustained ocular hypertension induces dendritic degeneration of mouse retinal ganglion cells that depends on cell type and location. Investig. Ophthalmol. Vis. Sci. 2013, 54, 1106–1117. [Google Scholar] [CrossRef]
- Tan, O.; Li, G.; Lu, A.T.; Varma, R.; Huang, D. Mapping of macular substructures with optical coherence tomography for glaucoma diagnosis. Ophthalmology 2008, 115, 949–956. [Google Scholar] [CrossRef]
- Kergoat, H.; Hérard, M.E.; Lemay, M. RGC sensitivity to mild systemic hypoxia. Investig. Ophthalmol. Vis. Sci. 2006, 47, 5423–5427. [Google Scholar] [CrossRef]
- Kaur, C.; Foulds, W.S.; Ling, E.A. Hypoxia-ischemia and retinal ganglion cell damage. Clin. Ophthalmol. 2008, 2, 879–889. [Google Scholar] [CrossRef] [PubMed]
- Janáky, M.; Grósz, A.; Tóth, E.; Benedek, K.; Benedek, G. Hypobaric hypoxia reduces the amplitude of oscillatory potentials in the human ERG. Doc. Ophthalmol. 2007, 114, 45–51. [Google Scholar] [CrossRef] [PubMed]
- Hughes, W.F. Quantitation of ischemic damage in the rat retina. Exp. Eye Res. 1991, 53, 573–582. [Google Scholar] [CrossRef]
- Hood, D.C.; Anderson, S.; Rouleau, J.; Wenick, A.S.; Grover, L.K.; Behrens, M.M.; Odel, J.G.; Lee, A.G.; Kardon, R.H. Retinal nerve fiber structure versus visual field function in patients with ischemic optic neuropathy. Ophthalmology 2008, 115, 904–910. [Google Scholar] [CrossRef] [PubMed]
- Akbari, M.; Abdi, P.; Fard, M.A.; Afzali, M.; Ameri, A.; Yazdani-Abyaneh, A.; Mohammadi, M.; Moghimi, S. Retinal ganglion cell loss precedes retinal nerve fiber thinning in nonarteritic anterior ischemic optic neuropathy. J. Neuroophthalmol. 2016, 36, 141–146. [Google Scholar] [CrossRef]
- Hong, D.; Bosc, C.; Chiambaretta, F.J. Progression of nerve fiber layer defects in retrobulbar optic neuritis by the macular ganglion cell complex. Fr. Ophtalmol. 2017, 40, 777–787. [Google Scholar] [CrossRef]
- Elbendary, A.M.; Abd El-Latef, M.H.; Elsorogy, H.I.; Enaam, K.M. Diagnostic accuracy of ganglion cell complex substructures in different stages of primary open-angle glaucoma. Can. J. Ophthalmol. 2017, 52, 355–360. [Google Scholar] [CrossRef]
- Zivkovic, M.; Dayanir, V.; Zlatanovic, M.; Zlatanovic, G.; Jaksic, V.; Jovanovic, P.; Radenkovic, M.; Djordjevic-Jocic, J.; Stankovic-Babic, G.; Jovanovic, S. Ganglion Cell-Inner Plexiform Layer Thickness in Different Glaucoma Stages Measured by Optical Coherence Tomography. Ophthalmic. Res. 2018, 59, 148–154. [Google Scholar] [CrossRef]
- Asanad, S.; Tian, J.J.; Frousiakis, S.; Jiang, J.P.; Kogachi, K.; Felix, C.M.; Fatemeh, D.; Irvine, A.G.; Ter-Zakarian, A.; Falavarjani, K.G.; et al. Optical Coherence Tomography of the Retinal Ganglion Cell Complex in Leber’s Hereditary Optic Neuropathy and Dominant Optic Atrophy. Curr. Eye Res. 2019, 44, 638–644. [Google Scholar] [CrossRef]
- de Aguiar Remigio, M.C.; Brandt, C.T.; Santos, C.C.; Arantes, T.E.; de Aguiar, M.I. Macular and peripapillary retinal nerve fibre layer thickness in patients with cyanotic congenital heart disease. Eye Lond. 2015, 29, 465–468. [Google Scholar] [CrossRef][Green Version]
- Mojtaba Golzan, S.; Leaney, J.; Cordina, R.; Avolio, A.; Celermajer, D.S.; Graham, S.L. Spontaneous retinal venous pulsatility in patients with cyanotic congenital heart disease. Heart Vessel. 2012, 27, 618–623. [Google Scholar] [CrossRef] [PubMed]
- Johns, K.J.; Johns, J.A.; Feman, S.S. Retinal vascular abnormalities in patients with coarctation of the aorta. Arch. Ophthalmol. 1991, 109, 1266–1268. [Google Scholar] [CrossRef] [PubMed]
- Mansour, A.M.; Bitar, F.F.; Traboulsi, E.I.; Kassak, K.M.; Obeid, M.Y.; Megarbane, A.; Salti, H.I. Ocular pathology in congenital heart disease. Eye Lond. 2005, 19, 29–34. [Google Scholar] [CrossRef] [PubMed]
- Tsui, I.; Shamsa, K.; Perloff, J.K.; Lee, E.; Wirthlin, R.S.; Schwartz, S.D. Retinal vascular patterns in adults with cyanotic congenital heart disease. Semin. Ophthalmol. 2009, 24, 262–265. [Google Scholar] [CrossRef] [PubMed]
- Mathew, T.; Williams, L.; Navaratnam, G.; Rana, B.; Wheeler, R.; Collins, K.; Harkness, A.; Jones, R.; Knight, D.; O’Gallagher, K.; et al. Diagnosis and assessment of dilated cardiomyopathy: A guideline protocol from the British Society of Echocardiography. Echo Res. Pract. 2017, 4, G1–G13. [Google Scholar] [CrossRef]
- Japp, A.G.; Gulati, A.; Cook, S.A.; Cowie, M.R.; Prasad, S.K. The Diagnosis and Evaluation of Dilated Cardiomyopathy. J. Am. Coll. Cardiol. 2016, 67, 2996–3010. [Google Scholar] [CrossRef]
- Puggia, I.; Merlo, M.; Barbati, G.; Rowland, T.J.; Stolfo, D.; Gigli, M.; Ramani, F.; Di Lenarda, A.; Mestroni, L.; Sinagra, G. Natural History of Dilated Cardiomyopathy in Children. J. Am. Heart Assoc. 2016, 5, e003450. [Google Scholar] [CrossRef]
- Fadl, S.; Wåhlander, H.; Fall, K.; Cao, Y.; Sunnegårdh, J. The highest mortality rates in childhood dilated cardiomyopathy occur during the first year after diagnosis. Acta Paediatr. 2018, 107, 672–677. [Google Scholar] [CrossRef]
- Burke, M.A.; Cook, S.A.; Seidman, J.G.; Seidman, C.E. Clinical and Mechanistic Insights into the Genetics of Cardiomyopathy. J. Am. Coll. Cardiol. 2016, 68, 2871–2886. [Google Scholar] [CrossRef]
- Lipshultz, S.E.; Cochran, T.R.; Briston, D.A.; Brown, S.R.; Sambatakos, P.J.; Miller, T.L.; Carrillo, A.A.; Corcia, L.; Sanchez, J.E.; Diamond, M.B.; et al. Pediatric cardiomyopathies: Causes, epidemiology, clinical course, preventive strategies and therapies. Future Cardiol. 2013, 9, 817–848. [Google Scholar] [CrossRef]
- Price, J.F.; Jeewa, A.; Denfield, S.W. Clinical Characteristics and Treatment of Cardiomyopathies in Children. Curr. Cardiol. Rev. 2016, 12, 85–98. [Google Scholar] [CrossRef] [PubMed]
- Vikhorev, P.G.; Vikhoreva, N.N. Cardiomyopathies and Related Changes in Contractility of Human Heart Muscle. Int. J. Mol. Sci. 2018, 19, 2234. [Google Scholar] [CrossRef]
- McNally, E.M.; Mestroni, L. Dilated Cardiomyopathy: Genetic Determinants and Mechanisms. Circ. Res. 2017, 121, 731–748. [Google Scholar] [CrossRef]
- Alm, A.; Bill, A. Ocular and optic nerve blood flow at normal and increased intraocular pressures in monkeys (Macaca irus): A study with radioactively labelled microspheres including flow determinations in brain and someother tissues. Exp. Eye Res. 1973, 15, 15–19. [Google Scholar] [CrossRef]
- Ames, A. Energy requirements of CNS cells as related to their function and to their vulnerability to ischemia: A commentary based on studies on retina. Can. J. Physiol. Pharmacol. 1992, 70, S158–S164. [Google Scholar] [CrossRef] [PubMed]
- Osborne, N.N.; Casson, R.J.; Wood, J.P.; Chidlow, G.; Graham, M.; Melena, J. Retinal ischemia: Mechanisms of damage and potential therapeutic strategies. Prog. Retin. Eye Res. 2004, 23, 91–147. [Google Scholar] [CrossRef] [PubMed]
- Wangasa-Wirawa, N.D.; Linsenmeier, R.A. Retinal Oxygen Fundamental and Clinical. Arch. Ophthalmol. 2003, 121, 547–557. [Google Scholar] [CrossRef]
- Flammer, J.; Konieczka, K.; Bruno, R.M.; Virdis, A.; Flammer, A.J.; Taddei, S. The eye and the heart. Eur. Heart J. 2013, 34, 1270–1278. [Google Scholar] [CrossRef] [PubMed]
- Campbell, J.P.; Zhang, M.; Hwang, T.S.; Bailey, S.T.; Wilson, D.J.; Jia, Y.; Huang, D. Detailed Vascular Anatomy of the Human Retina by Projection-Resolved Optical Coherence Tomography Angiography. Sci. Rep. 2017, 7, 42201. [Google Scholar] [CrossRef]
- Choi, B.R.; Kim, J.S.; Yang, Y.J.; Park, K.M.; Lee, C.W.; Kim, Y.H.; Hong, M.K.; Song, J.K.; Park, S.W.; Park, S.J.; et al. Factors associated with decreased cerebral blood flow in congestive heart failure secondary to idiopathic dilated cardiomyopathy. Am. J. Cardiol. 2006, 97, 1365–1369. [Google Scholar] [CrossRef]
- Chidlow, G.; Osborne, N.N. Rat retinal ganglion cell loss caused by kainate, NMDA and ischemia correlates with a reduction in mRNA and protein of Thy-1 and neurofilament light. Brain Res. 2003, 963, 298–306. [Google Scholar] [CrossRef]
- Wang, X.; Niwa, M.; Hara, A.; Matsuno, H.; Kawase, K.; Kozawa, O.; Mow, H.; Uematsu, T. Neuronal degradation in mouse retina after a transient ischemia and protective effect of hypothermia. Neurol. Res. 2002, 24, 730–735. [Google Scholar] [CrossRef] [PubMed]
- Lafuente, M.P.; Villegas-Perez, M.P.; Sellés-Navarro, I.; Mayor-Torroglosa, S.; Miralles de Imperial, J.; Vidal-Sanz, M. Retinal ganglion cell death after acute retinal ischemia is an ongoing process whose severity and duration depends on the duration of the insult. Neuroscience 2002, 109, 157–168. [Google Scholar] [CrossRef]
- Nakahara, T.; Hoshino, M.; Hoshino, S.; Mori, A.; Sakamoto, K.; Ishii, K. Structural and functional changes in retinal vasculature induced by retinal ischemia-reperfusion in rats. Exp. Eye Res. 2015, 135, 134–145. [Google Scholar] [CrossRef]
- Almeida-Freitas, D.B.; Meira-Freitas, D.; Melo, L.A., Jr.; Paranhos, A., Jr.; Iared, W.; Ajzen, S. Color Doppler imaging of the ophthalmic artery in patients with chronic heart failure. Arq. Bras. Oftalmol. 2011, 74, 326–329. [Google Scholar] [CrossRef]
- Neufeld, A.H.; Kawai, S.I.; Das, S.; Vora, S.; Gachie, E.; Connor, J.R.; Manning, P.T. Loss of retinal ganglion cells following retinal ischemia: The role of inducible nitric oxide synthase. Exp. Eye Res. 2002, 75, 521–528. [Google Scholar] [CrossRef]
- Caprara, C.; Grimm, C. From oxygen to erythropoietin: Relevance of hypoxia for retinal development, health and disease. Prog. Retin. Eye Res. 2012, 31, 89–119. [Google Scholar] [CrossRef]
- Garcia-Martin, E.; Ruiz-de Gopegui, E.; León-Latre, M.; Otin, S.; Altemir, I.; Polo, V.; Larrosa, J.M.; Cipres, M.; Casasnovas, J.A.; Pablo, L.E. Influence of cardiovascular condition on retinal and retinal nerve fiber layer measurements. PLoS ONE 2017, 12, e0189929. [Google Scholar] [CrossRef]
- Neoh, Y.L.; Neoh, P.F.; Salleh, A.; Yusof, Z.B.; Gurusamy, B.; Ahmad Tajudin, L.S. Triple Vessel Coronary Artery Disease and Retinal Nerve Fibre Layer Thickness. Ann. Acad. Med. Singap. 2018, 47, 226–229. [Google Scholar]
- Meira-Freitas, D.; Alberto, S.; Melo, L.; Almeida-Freitas, D.; Paranhos, A. Glaucomatous optic nerve head alterations in patients with chronic heart failure. Clin Ophthalmol. 2012, 6, 623–629. [Google Scholar] [CrossRef][Green Version]
- Bayramoğlu, S.; Özbay, S.; Sayın, N. Effect of diastolic heart dysfunction due to hypertrophic cardiomyopathy on choroidal thickness. Kanuni Sultan Suleyman. 2018, 10, 143–148. [Google Scholar] [CrossRef][Green Version]
- Brinchmann-Hansen, O.; Myhre, K. Vascular response of retinal arteries and veins to acute hypoxia of 8,000, 10,000, 12,500, and 15,000 feet of simulated altitude. Aviat. Space Environ. Med. 1990, 61, 112–116. [Google Scholar] [PubMed]
- Fallon, T.J.; Maxwell, D.; Kohner, E.M. Retinal vascular autoregulation in conditions of hyperoxia and hypoxia using the blue field entoptic phenomenon. Ophthalmology 1985, 92, 701–705. [Google Scholar] [CrossRef]
- Kuwabara, T.; Cogan, D. Retinal glycogen. Trans. Am. Ophthalmol. Soc. 1961, 59, 106–110. [Google Scholar] [CrossRef]
- Wasilewa, P.; Hockwin, O.; Korte, I. Glycogen concentration changes in retina, vitreous body and other eye tissues caused by disturbances of blood circulation Albrecht. Albrecht von Graefes Archiv für Klinische und Experimentelle Ophthalmologie 1976, 199, 115–120. [Google Scholar] [CrossRef]
- Stone, J.; Maslim, J.; Valter-Kocsi, K.; Mervin, K.; Bowers, F.; Chu, Y.; Barnett, N.; Provis, J.; Lewis, G.; Fisher, S.K.; et al. Mechanisms of photoreceptor death and survival in mammalian retina. Prog. Retin. Eye Res. 1999, 18, 689–735. [Google Scholar] [CrossRef]
- Hirasawa, K.; Shoji, N. Association between ganglion cell complex and axial length. Jpn. J. Ophthalmol. 2013, 57, 429–434. [Google Scholar] [CrossRef]
- Takeyama, A.; Kita, Y.; Kita, R.; Tomita, G. Influence of axial length on ganglion cell complex (GCC) thickness and on GCC thickness to retinal thickness ratios in young adults. Jpn. J. Ophthalmol. 2014, 58, 86–93. [Google Scholar] [CrossRef]
- Zhao, Z.; Jiang, C. Effect of myopia on ganglion cell complex and peripapillary retinal nerve fibre layer measurements: A Fourier-domain optical coherence tomography study of young. Chinese persons. Clin. Exp. Ophthalmol. 2013, 41, 561–566. [Google Scholar] [CrossRef]
- Sezgin Akcay, B.I.; Gunay, B.O.; Kardes, E.; Unlu, C.; Ergin, A. Evaluation of the Ganglion Cell Complex and Retinal Nerve Fiber Layer in Low, Moderate, and High Myopia: A Study by RTVue Spectral Domain Optical Coherence Tomography. Semin. Ophthalmol. 2017, 32, 682–688. [Google Scholar] [CrossRef]
- Gao, H.; Hollyfield, J.G. Aging of the human retina: Differential loss of neurons and retinal pigment epithelial cells. Investig. Ophthalmol. Vis. Sci. 1992, 33, 1–17. [Google Scholar] [PubMed]
- Ooto, S.; Hangai, M.; Tomidokoro, A.; Saito, H.; Araie, M.; Otani, T.; Kishi, S.; Matsushita, K.; Maeda, N.; Shirakashi, M.; et al. Effects of age, sex, and axial length on the three-dimensional profile of normal macular layer structures. Investig. Ophthalmol. Vis. Sci. 2011, 52, 8769–8779. [Google Scholar] [CrossRef] [PubMed]
- Cheng, L.; Wang, M.; Deng, J.; Lv, M.; Jiang, W.; Xiong, S.; Sun, S.; Zhu, J.; Zou, H.; He, X.; et al. Macular Ganglion Cell-Inner Plexiform Layer, Ganglion Cell Complex, and Outer Retinal Layer Thicknesses in a Large Cohort of Chinese Children. Investig. Ophthalmol. Vis. Sci. 2019, 60, 4792–4802. [Google Scholar] [CrossRef]
- Shariati, M.A.; Park, J.H.; Liao, Y.J. Optical coherence tomography study of retinal changes in normal aging and after ischemia. Investig. Ophthalmol. Vis. Sci. 2015, 56, 2790–2797. [Google Scholar] [CrossRef] [PubMed]
- Koh, V.; Tham, Y.C.; Cheung, C.Y.; Wong, W.L.; Baskaran, M.; Saw, S.M.; Wong, T.Y.; Aung, T. Determinants of ganglion cell-inner plexiform layer thickness measured by high definition optical coherence tomography. Investig. Ophthalmol. Vis. Sci. 2012, 53, 5853–5859. [Google Scholar] [CrossRef]

| Variable | Study Group | M | SD | 95% CI | Range | p |
|---|---|---|---|---|---|---|
| NT-proBNP (pg/mL) | DCM Group | 568.10 | 1045.27 | 177.79–958.41 | 15–3723 | - |
| LVEF (%) | DCM Group | 49.03 | 6.63 | 46.56–51.51 | 30–55 | - |
| Age (years) | DCM Group | 9.9 | 3.57 | 8.57–11.23 | 5–17 | 0.75 |
| Control group | 10.08 | 3.41 | 8.97–11.18 | 4–16 | ||
| Biometry (mm) | DCM Group | 22.17 | 0.88 | 21.85–22.5 | 20.615–24.08 | 0.11 |
| Control group | 22.46 | 0.65 | 22.26–22.67 | 21.1–23.795 | ||
| DCM Group | 0.75 | 1.14 | 0.32–1.17 | −2.00–3.00 | 0.47 | |
| spherical refractive error (Dsph) | Control group | 0.56 | 1.17 | 0.19–0.94 | −2.25–2.75 | |
| DCM Group | 0.17 | 0.29 | 0.06–0.28 | 0.00–1.25 | 0.08 | |
| cylindrical eye error (Dcyl) | Control group | 0.27 | 0.35 | 0.15–0.38 | 0.00–1.00 |
| Variable | Study Group | M | SD | 95% CI | Range | p |
|---|---|---|---|---|---|---|
| avgGCC (μm) | DCM group | 98.13 | 6.58 | 95.68–100.59 | 83.5–112 | 0.21 |
| Control group | 99.96 | 5.25 | 98.26–101.66 | 89–109 | ||
| supGCC (μm) | DCM group | 97.17 | 6.82 | 94.62–99.71 | 83–111 | 0.13 |
| Control group | 99.29 | 5.28 | 97.58–101.01 | 87.5–107.5 | ||
| infGCC (μm) | DCM group | 99.03 | 6.27 | 96.69–101.37 | 84.5–112.5 | 0.25 |
| Control group | 100.71 | 5.51 | 98.92–102.49 | 90–110.5 | ||
| FLV (%) | DCM group | 0.49 | 0.4 | 0.34–0.64 | 0.005–1.635 | |
| Control group | 0.4 | 0.39 | 0.27–0.53 | 0.015–1.59 | ||
| GLV (%) | DCM group | 2.1 | 2.73 | 1.08–3.12 | 0.005–11.5 | 0.09 |
| Control group | 1.3 | 1.71 | 0.75–1.86 | 0.015–6.335 |
© 2020 by the authors. Licensee MDPI, Basel, Switzerland. This article is an open access article distributed under the terms and conditions of the Creative Commons Attribution (CC BY) license (http://creativecommons.org/licenses/by/4.0/).
Share and Cite
Rakusiewicz, K.; Kanigowska, K.; Hautz, W.; Ziółkowska, L. Investigating Ganglion Cell Complex Thickness in Children with Chronic Heart Failure due to Dilated Cardiomyopathy. J. Clin. Med. 2020, 9, 2882. https://doi.org/10.3390/jcm9092882
Rakusiewicz K, Kanigowska K, Hautz W, Ziółkowska L. Investigating Ganglion Cell Complex Thickness in Children with Chronic Heart Failure due to Dilated Cardiomyopathy. Journal of Clinical Medicine. 2020; 9(9):2882. https://doi.org/10.3390/jcm9092882
Chicago/Turabian StyleRakusiewicz, Klaudia, Krystyna Kanigowska, Wojciech Hautz, and Lidia Ziółkowska. 2020. "Investigating Ganglion Cell Complex Thickness in Children with Chronic Heart Failure due to Dilated Cardiomyopathy" Journal of Clinical Medicine 9, no. 9: 2882. https://doi.org/10.3390/jcm9092882
APA StyleRakusiewicz, K., Kanigowska, K., Hautz, W., & Ziółkowska, L. (2020). Investigating Ganglion Cell Complex Thickness in Children with Chronic Heart Failure due to Dilated Cardiomyopathy. Journal of Clinical Medicine, 9(9), 2882. https://doi.org/10.3390/jcm9092882

